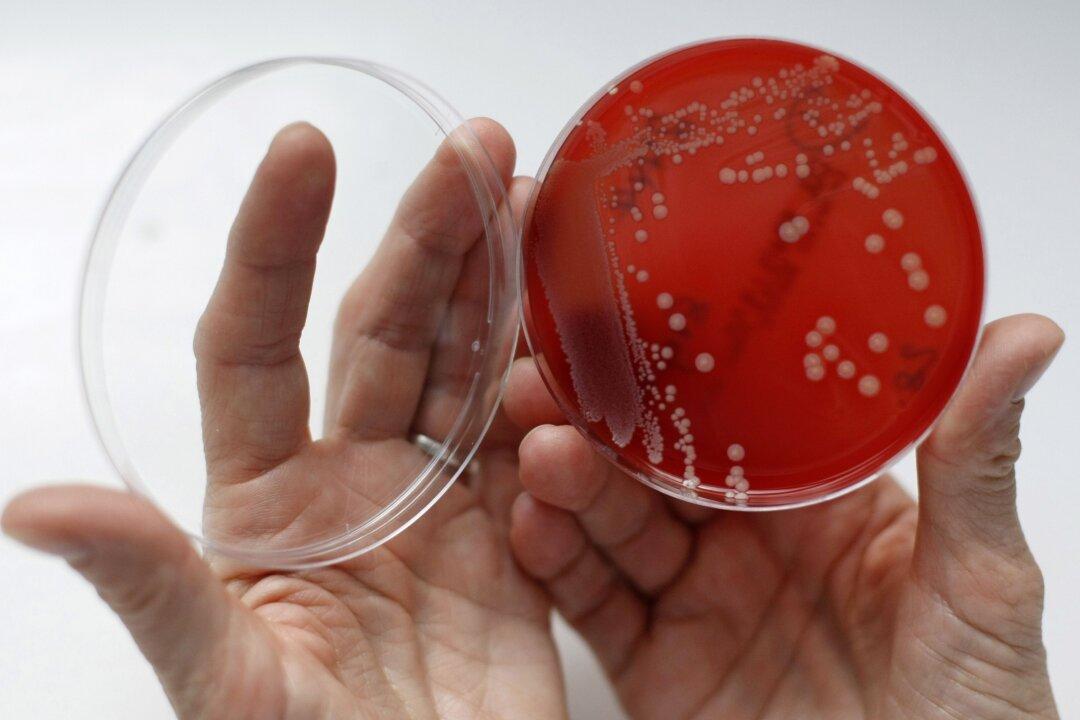
Multiple LAPD Officers Infected With Drug-Resistant MSRA: Reports

Multiple officers at the Los Angeles Police Department (LAPD) may have contracted MRSA, an antibiotic-resistant staph bacteria that can cause a highly contagious infection.
LAPD confirmed to several news agencies that some work areas may have been exposed to the bacteria but have since been disinfected. They did not provide any specific details about the exposure, reported Los Angeles Times.